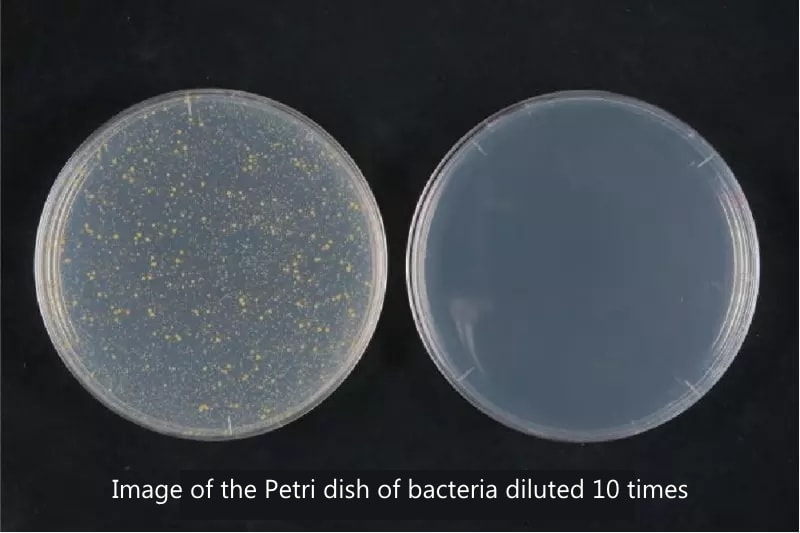

C-ENG's 3D net-like structure was created as a core material when the company was working with the Japan Highway Public Corporation (now NEXCO) to develop shock absorbers to be installed at expressway junctions and emergency parking lanes.
At the time, it was common knowledge worldwide that it was impossible to create a high-quality 3D net-like structure due to the characteristics of the resin used as a materal.
However, C-ENG's unique technical capabilities and know-how have overturned conventional wisdom around the world, and they began selling the products in 2000 as a cushioning material for bedding.
C-ENG's motto is "Coexistence with Nature." We believe that our mission is to leave behind a society in which future children can live in peace.
All of C-ENG’s 3D net-like structures are manufactured domestically and are made from safe and reliable materials. The safety of the materials is also confirmed in accordance with JIS standard testing and the Food Sanitation Act.
They are people-friendly, hygienic and safe to use.
In addition, it is an environmentally friendly material that does not produce dioxins when burned and can be recycled as a raw material.
3D net-like structures

A 3D net-like structure is a structure in which resin extruded into thread-like form is intertwined in three dimensions. By adjusting the type of resin, size, shape, hardness, fiber diameter, etc., it is possible to meet a variety of needs.
Manufacturing Patent
C-Eng has obtained patents for its 3D net-like structures in Japan and major overseas markets. Taking advantage of its excellent properties and functions, it is used in a variety of fields, not just in bedding.
【Domestic Patents】
・Japanese Patent No. 5986584
「3D mesh structure (polyethylene) for use in cushions, sofas, beds, etc.」
・Japanese Patent No. 61822249
「Three-dimensional mesh structure mattress (polyester)」
【Overseas Patents】
America, England, Germany, France, Netherlands, Poland, Sweden, Turkey, China, India, Thailand, South Korea, Philippines, Vietnam, Malaysia, Indonesia, Russia, Brazil
Raw materials used
- Polyethylene
- Green Polyethylene(GRECO)
- Recycled Polyethylene
- Polyester Elastomer
- polypropylene

GRECO is certified to comply with the Biomass Mark identification mark.
Product name: GRECO
Certification number: 220210
①Characteristics of polyethylene
Polyethylene is a synthetic resin produced from crude oil. It is easy to process and mold, lightweight, and has excellent waterproof and water-resistant properties.
- Cold resistance that can withstand temperatures as low as -20°C.
- Highly waterproof as it has almost no water absorption.
- High electrical insulation and does not conduct electricity.
- Highly resistant to chemicals.
- Excellent oil resistance.
②Characteristics of polyester elastomers
Thermoplastic polyester elastomers with flexibility and excellent durability.
They combine flexibility not found in ordinary plastics with physical and chemical properties not found in rubber.
- High mechanical strength and well-balanced mechanical performance.
- Excellent bending resistance.
- Stable performance at both high and low temperatures.
- Oil, chemical, ozone, and water-resistant (at normal temperature).
- Excellent flexibility and bending resistance at low temperatures.
- Excellent impact resistance and rebound resilience.
- Good sound-proofing performance, sliding properties, and abrasion resistance.
③Characteristics of polypropylene
Polypropylene(PP) is also a synthetic resin produced from crude oil. It has good processability, is lightweight, waterproof, and has excellent chemical resistance.
- Excellent heat resistance, chemical resistance, mechanical strength, insulation, and heat insulation.
- Has a low specific gravity among plastics.
- Has a glossy surface, good appearance, and hardness.
- Good hinge properties, processability, and chemical and electrical properties.
Functional Materials
①Flame retardant
By adding flame retardants, it is possible to produce flame-retardant type materials. Flame-retardant types can be developed for polyester, polypropylene, and polyethylene.
【Flame retardant performance】
- UL-94 V Law: Compliant with V-2
- FMVSS302: Passed
- GB8410: Passed
*Flame retardant means that the material will not burn for five minutes, will not deform, melt, crack or develop any other damage that would be detrimental to fire safety, and will not emit smoke or gases that would be detrimental to evacuation.
②Antimicrobial
By adding a silver-based inorganic antibacterial agent to polyethylene, it is possible to impart antibacterial properties to the material. The applicable material has acquired the SIAA mark from the Council of Technology for Antibacterial Products.
*Silver-based inorganic antibacterial agents do not decompose or change in quality even at resin molding temperatures, do not elute due to organic solvents, and maintain antibacterial properties for a long period of time. They contain highly safe silver as their active ingredient and have many advantages over organic antibacterial agents, including safety, durability, and heat resistance.
③Colorability
It is possible to color materials for decorative, identification, and weather resistance purpose. Coloring is performed by mixing coloring agents into the resin during the molding process. Unlike external coloring, coloring is performed by mixing colorants together, resulting in even and uniform internal coloring.

Processing Technology
①Thermoforming
The thermoplasticity of resin can be used to deform it into any shape.
By pressing it into a mold in a high-temperature bath, it can be processed into a three-dimensional shape.
Maximum dimensions: thickness 150mm×width 650mm×length 850mm

②Ultrasonic processing
This is a processing technology that fuses materials together using frictional heat generated by ultrasonic vibrations. Unlike techniques that use sewing needles to make holes in materials, this technique does not use needles, so there is no risk of thread breakage or fraying. It is possible to fuse materials together or materials to fabrics.

③Die-cutting
By pressing materials with metal molds, it is possible to process it into various shapes. It may not be suitable for complex shapes, but since die-cutting molds are relatively inexpensive to produce compared to metal molds, it can reduce costs.
